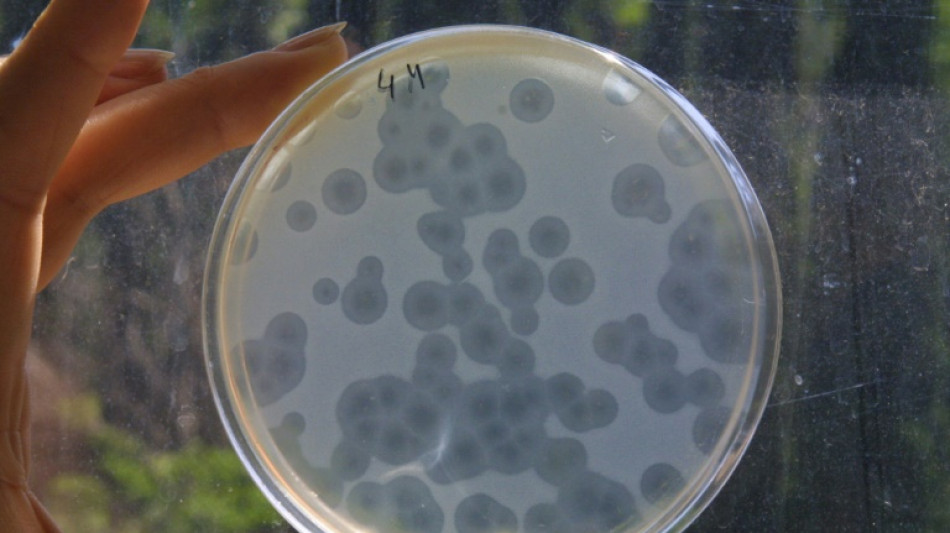
Las infecciones bacterianas son la segunda causa de muerte en el mundo

Las infecciones bacterianas son la segunda causa de muerte en el mundo
Las infecciones de origen bacteriano son la segunda causa de muertes en el mundo tras los problemas cardiovasculatorios, según un vasto estudio publicado el martes, que señala al estafilococo áureo y al neumococo como las bacterias más letales.
Este estudio publicado en la revista Lancet seleccionó una treintena de bacterias habitualmente implicadas en infecciones y evaluó cuántas muertes están asociadas a ellas.
Estos trabajos se enmarcaron en el Global Burden of Disease, un enorme programa de investigación financiado por la fundación Bill Gates y con un alcance sin igual por contar con miles de científicos en la mayoría de países.
"Las muertes asociadas a estas bacterias constituyen la segunda causa de decesos en el mundo" después de las enfermedades coronarias, que incluyen los infartos, concluyen los autores.
Las infecciones causaron 7,7 millones de decesos, lo que implica que una de cada ocho muertes se podía vincular a ellas, según los datos de 2019, en los que se basa el estudio.
De la treintena de bacterias estudiadas, cinco concentran más de la mitad de los casos: estafilococo áureo, E. coli, neumococo, Klebsiella pneumoniae y Pseudomonas aeruginosa.
El estafilococo áureo es "la principal causa bacteriana de deceso en 135 países", indica el estudio.
Sin embargo, entre los menores de cinco años, las infecciones por neumococo son las más letales.
Los investigadores subrayan que las infecciones bacterianas son una "prioridad urgente" en materia de sanidad pública y piden trabajar en la prevención de infecciones, un mejor uso de antibióticos y un empleo más eficaz de la vacunación.
P.Garcia--HHA



